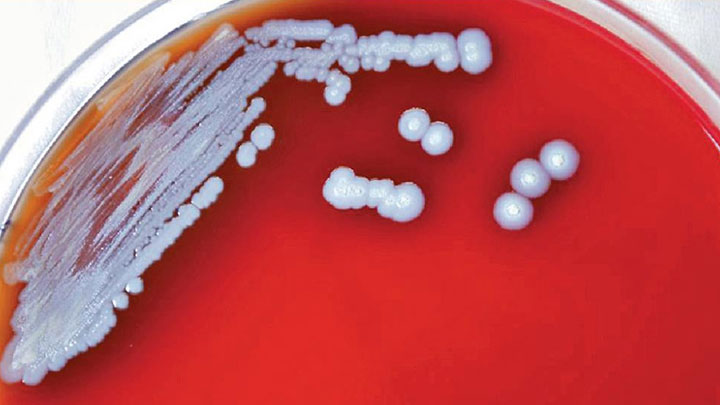
91歲類鼻疽男病人離世 本港今年累計10人病歿

行政長官李家超今日(17日)早上啓程前往泰國曼谷出席亞太經濟合作組織(APEC)第二十九次領導人非正式會議。李家超在香港國際機場會見傳媒時表示,會利用這個機會說好香港故事。
據悉,這次會議將會有21個經濟體的領袖出席,主題包括開放和聯繫。李家超指,希望這次出席會議向世界展示香港經過三年的疫情困擾後,已經開放,重返舞台。
他續指,香港背靠祖國、聯通國際,有得天獨厚的優勢,亦是唯一一個有中國優勢和世界優勢共同存在的城市。香港的吸引力和競爭力亦增強起來,包括將會成為中西文化藝術交流中心,亦會成為國際創科中心等。據了解,李家超此行帶領約20位商界代表,包括金融、專業人士以及貿易界別。
行程方面,李家超指今天最主要出席由大會舉辦的晚宴,正式會議在18日和19日舉行,接下來的周日(20日)李家超將會留在曼谷,與商務代表團接觸當地的不同人士。(視頻:羅璇)